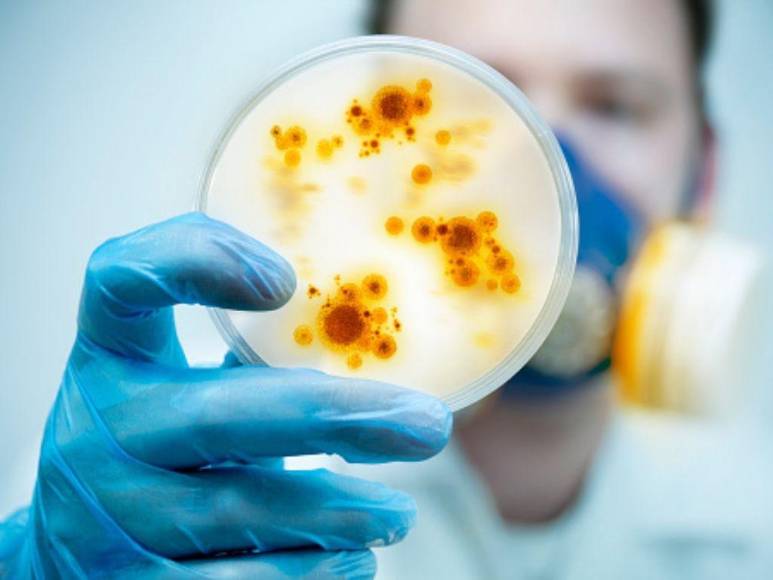
Viruela del mono ya está en Centroamérica, Costa Rica confirmó su primer caso sospechoso

Viruela del mono ya está en Centroamérica, Costa Rica confirmó su primer caso sospechoso
-

La enfermedad de la viruela del mono se ha expandido con facilidad por diversos países de América Latina y en las últimas horas se reportó el primer caso en Costa Rica, lo que ha aumentado las alertas de Honduras y demás naciones vecinas. Aquí te contamos más sobre el tema.
01/06/2022 - 00:001 / 16 -

La enfermedad viral fue detectada en humanos en 1970, 12 años después de ser descubierta en una especie de los monos llamada ‘macacos’.
01/06/2022 - 00:002 / 16 -

La viruela del mono está causada por un virus zoonótico, es decir, que tiene origen animal pero puede transmitirse de animales a humanos.
01/06/2022 - 00:003 / 16 -

Hace aproximadamente dos semanas, Europa y Estados Unidos recibieron una alerta de la Organización Mundial de la Salud (OMS) advirtiendo sobre la expansión de la enfermedad.
01/06/2022 - 00:004 / 16 -

Pese a que no es tan contagiosa como el covid-19, la viruela del mono es motivo de preocupación de muchos países como Honduras, donde el sistema de salud es débil.
01/06/2022 - 00:005 / 16 -

Estados Unidos y otros países de América han reportado varios casos, así como México, Argentina y Costa Rica en los últimos días.
01/06/2022 - 00:006 / 16 -

Argentina confirmó el pasado 27 de mayo a un paciente con la enfermedad, mientras que el fin de semana México fue el segundo.
01/06/2022 - 00:007 / 16 -

Por su parte, Costa Rica confirmó el primer caso sospechoso de la enfermedad este miércoles.
01/06/2022 - 00:008 / 16 -

Según informaron, se trataría de una joven de origen noruego que ingresó a Costa Rica el 22 de mayo junto a seis personas más, quienes también están en aislamiento.
01/06/2022 - 00:009 / 16 -

Detallaron que la paciente tenía fiebre y lesiones en las manos hace cinco días, por lo que fue llevada a un centro asistencial donde inició la investigación del caso.
01/06/2022 - 00:0010 / 16 -

Y es que fiebre, dolor de cabeza, dolores musculares, dolor de espalda, ganglios linfáticos inflamados, escalofríos y agotamiento son algunos síntomas de la viruela del mono.
01/06/2022 - 00:0011 / 16 -

Algunas de las medidas para evitar contagiarse son: evitar contacto con ciertos animales salvajes, cuidar a las mascotas expuestas, evitar interacciones con personas infectadas, no compartir objetos contaminados ni espacios con personas positivas a la enfermedad.
01/06/2022 - 00:0012 / 16 -

Pese a que no es un virus mortal, puede ocasionar cientos de casos en unas semanas.
01/06/2022 - 00:0013 / 16 -

A diferencia de la viruela, la viruela del mono también causa inflamación de los ganglios linfáticos.
01/06/2022 - 00:0014 / 16 -

A los pocos días del inicio de la fiebre, los pacientes desarrollan un sarpullido, que a menudo comienza en la cara y luego se extiende a otras partes del cuerpo. Las lesiones crecen hasta convertirse en pústulas que contienen líquido y forman una costra.
01/06/2022 - 00:0015 / 16 -

Los expertos recomiendan tomar las medidas adecuadas y mantener la calma.
01/06/2022 - 00:0016 / 16